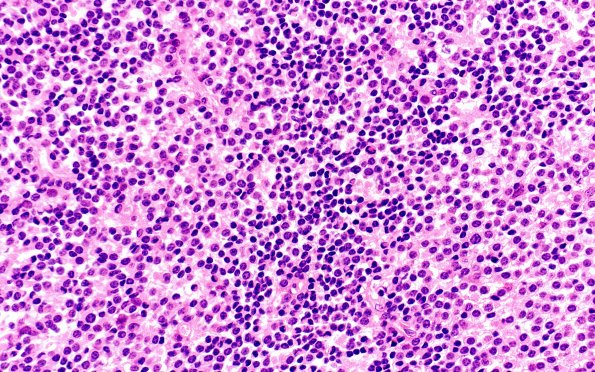
2B4 Pineal Anlage Tumor (Case 2) B3 H&E 40X

Table of Contents
Washington University Experience | NEOPLASMS (PINEAL) | Pineal Anlage Tumor | 2B4 Pineal Anlage Tumor (Case 2) B3 H&E 40X
Some areas hint at a more undifferentiated pattern of growth that does not demonstrate proliferative activity expected in an embryonal growth pattern. (H&E)